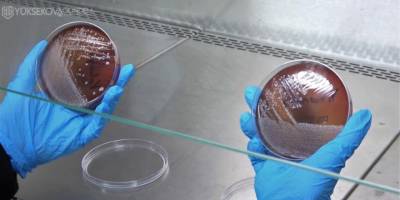
Yıkanan veya kolonya sıkılan maskede korkutan sonuç

- Yüksekova: Aynı Aileden 3 Kişi Yan Yana Toprağa Verildi
- Balıkesir'de 6.1 büyüklüğünde deprem
- Hakkari-Van kara yolunda kaza: 3 Ölü, 3 Yaralı
- PKK: Tüm güçlerimizi Türkiye'den çekiyoruz
- Ailenin Şüphelendiği Bölgede Arama Yapıldı: İbrahim’den Hala İz Yok
- Yüksekova’da Mevsimin İlk Karı Cilo Dağı’nı Beyaza Bürüdü
- Yüksekova’da Trafo Alev Alev Yandı!
- Hakkari'de İŞKUR Kurası Çekildi, işte sonuçlar...
- Yüksekova’da İlk Kez Denenen Dünyanın En Pahalı Bitkisi “Safran” Hasat Edildi
- İŞKUR Hakkari’de 3 bin kişilik alım yapacak